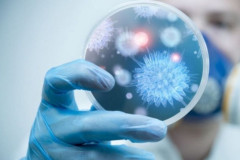

Lifestyle
 Իմունային համակարգը կարգավորելու համար ճակնդեղը լավագույն տարբերակն է. ահա թե ին...
Իմունային համակարգը կարգավորելու համար ճակնդեղը լավագույն տարբերակն է. ահա թե ին...
 10 ֆիլմ, որոնք հետաքրքիր կդարձնեն տանը անցկացրած ժամանակը. 2020-ին ֆիլմերի պակաս...
10 ֆիլմ, որոնք հետաքրքիր կդարձնեն տանը անցկացրած ժամանակը. 2020-ին ֆիլմերի պակաս...
 Ինչպիսի տեսք ունի 110 միլիոն դոլար արժողությամբ նոր, շքեղ մասնավոր ինքնաթիռը ներ...
Ինչպիսի տեսք ունի 110 միլիոն դոլար արժողությամբ նոր, շքեղ մասնավոր ինքնաթիռը ներ...
 Լուսանկարում երկու կատու կա. միայն ամենաուշադիր մարդիկ են կարողանում դրանց գտնել...
Լուսանկարում երկու կատու կա. միայն ամենաուշադիր մարդիկ են կարողանում դրանց գտնել...
 4-ամյա տղան հաղթահարել է գլխուղեղի քաղցկեղի հազվագյուտ տեսակը
4-ամյա տղան հաղթահարել է գլխուղեղի քաղցկեղի հազվագյուտ տեսակը
 Թաքնված նկարահանում. Տան աշխատակցուհին չգիտեր տեսախցիկի մասին. Տեսեք, թե ինչով է...
Թաքնված նկարահանում. Տան աշխատակցուհին չգիտեր տեսախցիկի մասին. Տեսեք, թե ինչով է...
 Այս փոքրիկը անհետացել էր իր սենյակում. 2 տարի անց ծնողները գտան սա պահարանում և ...
Այս փոքրիկը անհետացել էր իր սենյակում. 2 տարի անց ծնողները գտան սա պահարանում և ...
 Պատահական արված լուսանկարն օգնել է 13-ամյա աղջկան մուրացկանից վերածվել հեռուստատ...
Պատահական արված լուսանկարն օգնել է 13-ամյա աղջկան մուրացկանից վերածվել հեռուստատ...
 Կորոնավիրուսը 10 օրվա ընթացքում սպանել է կնոջն ու նրա 3 որդիներին. The Mirror
Կորոնավիրուսը 10 օրվա ընթացքում սպանել է կնոջն ու նրա 3 որդիներին. The Mirror
 Գիտնականները զգուշացնում են. Ահա, թե ինչ է տեղի ունենալու հունիսի 29-ին
Գիտնականները զգուշացնում են. Ահա, թե ինչ է տեղի ունենալու հունիսի 29-ին
 Գիտնականները ԲՑԺ պատվաստման եւ կորոնավիրուսի միջեւ կապ են գտել․ medRxiv
Գիտնականները ԲՑԺ պատվաստման եւ կորոնավիրուսի միջեւ կապ են գտել․ medRxiv
 Ինչպե՞ս է կարանտինն ազդում հոգեկան առողջության վրա
Ինչպե՞ս է կարանտինն ազդում հոգեկան առողջության վրա
 Ինչո՞ւ են իտալացիներն ավելի խոցելի կորոնավիրուսի նկատմամբ, եւ ի՞նչ դեր են խաղում...
Ինչո՞ւ են իտալացիներն ավելի խոցելի կորոնավիրուսի նկատմամբ, եւ ի՞նչ դեր են խաղում...
 Լիլի Մորտոյի սիրելին նրան $169000 արժողությամբ նվեր է մատուցել (տեսանյութ, լուսա...
Լիլի Մորտոյի սիրելին նրան $169000 արժողությամբ նվեր է մատուցել (տեսանյութ, լուսա...
 Մերի Մակարյանը ցույց է տվել իր €800 արժողությամբ Gucci կոշիկները
Մերի Մակարյանը ցույց է տվել իր €800 արժողությամբ Gucci կոշիկները
 Խոյեր, վստահեք ձեր ենթագիտակցությանը․ ապրիլի 11-ի աստղագուշակը
Խոյեր, վստահեք ձեր ենթագիտակցությանը․ ապրիլի 11-ի աստղագուշակը
 Ովքեր են կուբացի տրանսգենդերները, որոնք Երևանում էլեկտրաշոկի միջոցով թալանել են ...
Ովքեր են կուբացի տրանսգենդերները, որոնք Երևանում էլեկտրաշոկի միջոցով թալանել են ...
 Ինչու է վտանգավոր արցունքները զսպելը
Ինչու է վտանգավոր արցունքները զսպելը
 Կորոնավիրուսի նոր ախտանիշներ. Ինչպե՞ս է կորոնավիրուսն ազդում մաշկի վրա
Կորոնավիրուսի նոր ախտանիշներ. Ինչպե՞ս է կորոնավիրուսն ազդում մաշկի վրա
 Երգում է ինքնամեկուսացած Սպիտակցի Հայկոն (Video)
Երգում է ինքնամեկուսացած Սպիտակցի Հայկոն (Video)
 Հնարավո՞ր է կորոնավիրուսով վարակվել սնունդի միջոցով. MedicalXpress
Հնարավո՞ր է կորոնավիրուսով վարակվել սնունդի միջոցով. MedicalXpress
 Հումանիտար աղետ Էկվադորում. կորոնավիրուսի զոհերի դիերը թափված են փողոցներում
Հումանիտար աղետ Էկվադորում. կորոնավիրուսի զոհերի դիերը թափված են փողոցներում
 Սպասի հակագազս դնեմ․ Վանաձորցի կինը՝ ոստիկանին. (ՏԵՍԱՆՅՈՒԹ)
Սպասի հակագազս դնեմ․ Վանաձորցի կինը՝ ոստիկանին. (ՏԵՍԱՆՅՈՒԹ)
 Տղան ցած ընկավ ատրակցիոնից. Ամուր նյարդեր ունեցողների համար
Տղան ցած ընկավ ատրակցիոնից. Ամուր նյարդեր ունեցողների համար
 «Մի բան պիտի ասեմ, ինչի մասին խոսում եմ առհասարակ առաջին անգամ…». Իննա Խոջամիրյան
«Մի բան պիտի ասեմ, ինչի մասին խոսում եմ առհասարակ առաջին անգամ…». Իննա Խոջամիրյան
 Բնությունը բարկացած է. մահացու վտանգավոր շոգ կլինի մի շարք երկրներում, և կտուժի ...
Բնությունը բարկացած է. մահացու վտանգավոր շոգ կլինի մի շարք երկրներում, և կտուժի ...
 3 գործողություն, որոնք տղամարդիկ անում են միայն սիրուհիների համար. (ՖՈՏՈ)
3 գործողություն, որոնք տղամարդիկ անում են միայն սիրուհիների համար. (ՖՈՏՈ)
 Ինչպես էին Հին Չինաստանում ստուգում հարսնացուի կուսությունը
Ինչպես էին Հին Չինաստանում ստուգում հարսնացուի կուսությունը
 «Դե, սպասիր». մուլտֆիլմից՝ չափազանց պահանջված խաղ
«Դե, սպասիր». մուլտֆիլմից՝ չափազանց պահանջված խաղ
 Ահա, թե ինչ ուտելիք են տալիս բանտարկյալներին մահապատժից առաջ
Ահա, թե ինչ ուտելիք են տալիս բանտարկյալներին մահապատժից առաջ
 Հայոց ցեղասպանության ճանաչում և պետական շահերի առաջնահերթությունը. Մհեր Ավետիսյան
Հայոց ցեղասպանության ճանաչում և պետական շահերի առաջնահերթությունը. Մհեր Ավետիսյան ԱՄՆ-ում տան բակում տերերը հայտնաբերել են 2 000 տարվա հռոմեական տապանաքար, որը Երկրորդ համաշխարհայինի տարիներին անհետացել էր թանգարանից
ԱՄՆ-ում տան բակում տերերը հայտնաբերել են 2 000 տարվա հռոմեական տապանաքար, որը Երկրորդ համաշխարհայինի տարիներին անհետացել էր թանգարանից Հեռախոսների IMEI-ների բազան. մեզ վերահսկելու նոր քայլը ու ՍԴ քննությունը. Էդմոն Մարուքյան
Հեռախոսների IMEI-ների բազան. մեզ վերահսկելու նոր քայլը ու ՍԴ քննությունը. Էդմոն Մարուքյան ANCA-ն կոչ է անում արգելափակել Թուրքիային 700 մլն դոլարի ավիաշարժիչների վաճառքը
ANCA-ն կոչ է անում արգելափակել Թուրքիային 700 մլն դոլարի ավիաշարժիչների վաճառքը Նեթանյահուն հայտնել է, որ աջակցում է Իսրայելի ԱԳ նախարարի կողմից ներկայացվելիք Հայոց ցեղաuպանության ճանաչման նախագծին
Նեթանյահուն հայտնել է, որ աջակցում է Իսրայելի ԱԳ նախարարի կողմից ներկայացվելիք Հայոց ցեղաuպանության ճանաչման նախագծին Հայտնի է հուլիս ամսվա կենսաթոշակների վճարման օրը
Հայտնի է հուլիս ամսվա կենսաթոշակների վճարման օրը
 Uպանվել է Ուկրաինայի գլխավոր շտաբի գնդապետը, որը ներգրավված էր Ղրիմում ահաբեկչության նախապատրաստման մեջ․ ՌԴ ԱԴԾ
Uպանվել է Ուկրաինայի գլխավոր շտաբի գնդապետը, որը ներգրավված էր Ղրիմում ահաբեկչության նախապատրաստման մեջ․ ՌԴ ԱԴԾ Սպասվում է առանց տեղումների եղանակ․ օդի ջերմաստիճանը աստիճանաբար կբարձրանա 5-7 աստիճանով
Սպասվում է առանց տեղումների եղանակ․ օդի ջերմաստիճանը աստիճանաբար կբարձրանա 5-7 աստիճանով
 Հրազդանում «Opel Astra»-ն բшխվել է բաժանարար գոտու բետոնե արգելապատնեշին
Հրազդանում «Opel Astra»-ն բшխվել է բաժանարար գոտու բետոնե արգելապատնեշին Փաշինյանն ու Ալիևը հեգնում են հայ հանրությանը. այսօրվա ներկայացման հաշիվը մեր սերունդներն են փակելու. ադրբեջանագետ
Փաշինյանն ու Ալիևը հեգնում են հայ հանրությանը. այսօրվա ներկայացման հաշիվը մեր սերունդներն են փակելու. ադրբեջանագետ
 100-ամյա կինը բացահայտել է իր երկարակեցության գաղտնիքը՝ «Օրական 40 ծխախոտ և մուրաբա»
100-ամյա կինը բացահայտել է իր երկարակեցության գաղտնիքը՝ «Օրական 40 ծխախոտ և մուրաբա» Ռուսաստանի շրջաններից մեկում արձանագրվել է 23 անտառային հրդեհ՝ ավելի քան 3,6 հազար հա տարածքում
Ռուսաստանի շրջաններից մեկում արձանագրվել է 23 անտառային հրդեհ՝ ավելի քան 3,6 հազար հա տարածքում
 QS World University Rankings 2027․ Հայաստանի բարձրագույն կրթության ահազանգը․ Արմեն Մանվելյան
QS World University Rankings 2027․ Հայաստանի բարձրագույն կրթության ահազանգը․ Արմեն Մանվելյան Մերձավոր Արևելքում գտնվող ամերիկյան բազաները առաջիկա օրերին կհայտնվեն «իսկական դժnխքում»․ ԻՀՊԿ
Մերձավոր Արևելքում գտնվող ամերիկյան բազաները առաջիկա օրերին կհայտնվեն «իսկական դժnխքում»․ ԻՀՊԿ Ստորագրելով շրջանակային համաձայնագիրը Լիբանանի կառավարությունն ըստ էության ճանաչել է Իսրայելի պետությանը, ինչը մինչ այդ պաշտոնապես չէր արվում․ Արտակ Զաքարյան
Ստորագրելով շրջանակային համաձայնագիրը Լիբանանի կառավարությունն ըստ էության ճանաչել է Իսրայելի պետությանը, ինչը մինչ այդ պաշտոնապես չէր արվում․ Արտակ Զաքարյան
 Հորոսկոպ. Յուպիտերը Առյուծի մեջ բացում է բախտի շրջան բոլոր նշանների համար
Հորոսկոպ. Յուպիտերը Առյուծի մեջ բացում է բախտի շրջան բոլոր նշանների համար
 Իսրայելի կառավարությունը միաձայն ճանաչել է Հայոց ցեղաuպանությունը
Իսրայելի կառավարությունը միաձայն ճանաչել է Հայոց ցեղաuպանությունը
 ՍԴ վճռի սպասումով. ԲՀԿ-ի պայքարը շարունակվում է
ՍԴ վճռի սպասումով. ԲՀԿ-ի պայքարը շարունակվում է
 ԱՄՆ օդուժը հարվшծներ է հասցրել Իրանի հրթիռների և ԱԹՍ-ների պահեստավորման օբյեկտներին՝ հրադադարի համաձայնագիրը կրկին խախտելու պատճառով․ Թրամփ
ԱՄՆ օդուժը հարվшծներ է հասցրել Իրանի հրթիռների և ԱԹՍ-ների պահեստավորման օբյեկտներին՝ հրադադարի համաձայնագիրը կրկին խախտելու պատճառով․ Թրամփ Գեղարքունիքի մարզում` Գեղամավան գյուղի մուտքի մոտ, բшխվել են «Audi»-ն և «Lada»-ն․ 9 վիրավnրից 2-ն անչափահաս են
Գեղարքունիքի մարզում` Գեղամավան գյուղի մուտքի մոտ, բшխվել են «Audi»-ն և «Lada»-ն․ 9 վիրավnրից 2-ն անչափահաս են Լիբանանի վերաբերյալ շրջանակային համաձայնագիրը hարված է Իրանին․ Նեթանյահու
Լիբանանի վերաբերյալ շրջանակային համաձայնագիրը hարված է Իրանին․ Նեթանյահու
 Հայ Առաքելական եկեղեցին նշում է Սուրբ Աստվածածնի տուփի գյուտի տոնը
Հայ Առաքելական եկեղեցին նշում է Սուրբ Աստվածածնի տուփի գյուտի տոնը
 Ռուսաստանից Ադրբեջանի տարածքով 770 տոննա ցորեն է ուղարկվել Հայաստան
Ռուսաստանից Ադրբեջանի տարածքով 770 տոննա ցորեն է ուղարկվել Հայաստան
 Էդուարդ Սպերցյանը մոտ ժամանակներս կարիերան կշարունակի Սաուդյան Արաբիան ներկայացնող «Ալ-Ահլի» ակումբում
Էդուարդ Սպերցյանը մոտ ժամանակներս կարիերան կշարունակի Սաուդյան Արաբիան ներկայացնող «Ալ-Ահլի» ակումբում Տարադրամի փոխարժեքները` այսօր
Տարադրամի փոխարժեքները` այսօր
 Հունիսի 29-ին, 30-ին և հուլիսի 2-ին գազ չի լինելու
Հունիսի 29-ին, 30-ին և հուլիսի 2-ին գազ չի լինելու
 Արմավիրի մարզի Թաիրով բնակավայրում հրդեհ է բռնկվել շինհրապարակում
Արմավիրի մարզի Թաիրով բնակավայրում հրդեհ է բռնկվել շինհրապարակում
 Սառը ծովի ջուրը մեծացնում է էներգիայի արտադրությունը. Թայվանցի գիտնականները ապացուցել են լողացող արևային էլեկտրակայանների առավելությունները
Սառը ծովի ջուրը մեծացնում է էներգիայի արտադրությունը. Թայվանցի գիտնականները ապացուցել են լողացող արևային էլեկտրակայանների առավելությունները
 Վթարային ջրանջատում Էրեբունի վարչական շրջանում
Վթարային ջրանջատում Էրեբունի վարչական շրջանում
 Ուկրաինան հարվшծել է ՌԴ Կուբանի Սլավյանսկ քաղաքի նավթավերամշակման գործարանին
Ուկրաինան հարվшծել է ՌԴ Կուբանի Սլավյանսկ քաղաքի նավթավերամշակման գործարանին
 Փամբակ գետում վերսկսվել են երեկ կորած քաղաքացու որոնողական աշխատանքները
Փամբակ գետում վերսկսվել են երեկ կորած քաղաքացու որոնողական աշխատանքները
 ԱՄՆ ուժերը գիշերը հարվածել են Հորմուզի նեղուցում գտնվող 10 իրանական ռազմական օբյեկտների
ԱՄՆ ուժերը գիշերը հարվածել են Հորմուզի նեղուցում գտնվող 10 իրանական ռազմական օբյեկտների
 ԱՄՆ օդուժը հարվшծներ է հասցրել Իրանի հրթիռների և ԱԹՍ-ների պահեստավորման օբյեկտներին՝ հրադադարի համաձայնագիրը կրկին խախտելու պատճառով․ Թրամփ
ԱՄՆ օդուժը հարվшծներ է հասցրել Իրանի հրթիռների և ԱԹՍ-ների պահեստավորման օբյեկտներին՝ հրադադարի համաձայնագիրը կրկին խախտելու պատճառով․ Թրամփ
 Գերմանիայի Նաուբուրգ քաղաքում բացվել է Արմավիրի ծառուղի
Գերմանիայի Նաուբուրգ քաղաքում բացվել է Արմավիրի ծառուղի
 ԱՄՆ-ը կխթանի Հնդկաստանի և Վենեսուելայի միջև էներգետիկ համագործակցությունը. Ռուբիո
ԱՄՆ-ը կխթանի Հնդկաստանի և Վենեսուելայի միջև էներգետիկ համագործակցությունը. Ռուբիո Բալթյան երկրները Եվրամիությանը կոչ են արել հնարավորինս շուտ ներկայացնել ռուսական նավթից լիակատար հրաժարվելու ծրագիրը․ FT
Բալթյան երկրները Եվրամիությանը կոչ են արել հնարավորինս շուտ ներկայացնել ռուսական նավթից լիակատար հրաժարվելու ծրագիրը․ FT Վիճաբանություն և ծեծկռտուք՝ Արարատի մարզում. 4 անձ է ձերբակալվել
Վիճաբանություն և ծեծկռտուք՝ Արարատի մարզում. 4 անձ է ձերբակալվել Ոչնչացվել է 25 տոննա մսամթերք. ՍԱՏՄ
Ոչնչացվել է 25 տոննա մսամթերք. ՍԱՏՄ Ադրբեջանական լրատվամիջոցները հիստերիայի մեջ են ընկել ռուսական հեռուստաալիքի ռեպորտաժում Արցախի դրոշով թևանշանի պատճառով
Ադրբեջանական լրատվամիջոցները հիստերիայի մեջ են ընկել ռուսական հեռուստաալիքի ռեպորտաժում Արցախի դրոշով թևանշանի պատճառով Ինչպես է Զիգմունդ Ֆրոյդի թոռը հոգնած պետական ծառայողին վերածել 39 միլիոն դոլար արժողությամբ գլուխգործոցի
Ինչպես է Զիգմունդ Ֆրոյդի թոռը հոգնած պետական ծառայողին վերածել 39 միլիոն դոլար արժողությամբ գլուխգործոցի  Վրաստանում թմրամիջոցների մաքսանենգության և իրացման գործով Թուրքիայի և Ճապոնիայի քաղաքացիներ են ձերբակալվել
Վրաստանում թմրամիջոցների մաքսանենգության և իրացման գործով Թուրքիայի և Ճապոնիայի քաղաքացիներ են ձերբակալվել Պայծառ կապույտ մազեր և փիրսինգ. Նորթ Ուեսթը զարմացրել է Փարիզի նորաձևության շաբաթվա հանդիսատեսին
Պայծառ կապույտ մազեր և փիրսինգ. Նորթ Ուեսթը զարմացրել է Փարիզի նորաձևության շաբաթվա հանդիսատեսին Երեկվա փակ հանդիպումից հատվածներ․ Նարեկ Կարապետյանը տեսանյութ է հրապարակել
Երեկվա փակ հանդիպումից հատվածներ․ Նարեկ Կարապետյանը տեսանյութ է հրապարակել Դուք եղել եք, կաք և մնալու եք շրիշակից ցածր. Մարիաննա Ղահրամանյան
Դուք եղել եք, կաք և մնալու եք շրիշակից ցածր. Մարիաննա Ղահրամանյան Մեսսին Հորդանանի դեմ խաղը կսկսի պահեստայինների նստարանից
Մեսսին Հորդանանի դեմ խաղը կսկսի պահեստայինների նստարանից
 ԱՄՆ ԶՈւ-ն հայտնել են Իրանին hարվածելու մասին
ԱՄՆ ԶՈւ-ն հայտնել են Իրանին hարվածելու մասին
 Մեկ տարի անց․ պայքարը Հայ Առաքելական Եկեղեցու շուրջ շարունակվում է․ Արմեն Հովասափյան
Մեկ տարի անց․ պայքարը Հայ Առաքելական Եկեղեցու շուրջ շարունակվում է․ Արմեն Հովասափյան  Փամբակ գետում հայտնաբերվել է մարմին
Փամբակ գետում հայտնաբերվել է մարմին
 Մերձավոր Արևելքում խաղաղությունը դեռևս հեռավոր նպատակ է. Արտակ Զաքարյան
Մերձավոր Արևելքում խաղաղությունը դեռևս հեռավոր նպատակ է. Արտակ Զաքարյան Ջերմաստիճանը կհասնի 35-36 աստիճանի. Գագիկ Սուրենյան
Ջերմաստիճանը կհասնի 35-36 աստիճանի. Գագիկ Սուրենյան

 Փաշինյանն ու Ալիևը հեգնում են հայ հանրությանը. այսօրվա ներկայացման հաշիվը մեր սերունդներն են փակելու. ադրբեջանագետ
Փաշինյանն ու Ալիևը հեգնում են հայ հանրությանը. այսօրվա ներկայացման հաշիվը մեր սերունդներն են փակելու. ադրբեջանագետ
 Ստորագրելով շրջանակային համաձայնագիրը Լիբանանի կառավարությունն ըստ էության ճանաչել է Իսրայելի պետությանը, ինչը մինչ այդ պաշտոնապես չէր արվում․ Արտակ Զաքարյան
Ստորագրելով շրջանակային համաձայնագիրը Լիբանանի կառավարությունն ըստ էության ճանաչել է Իսրայելի պետությանը, ինչը մինչ այդ պաշտոնապես չէր արվում․ Արտակ Զաքարյան
 ՍԴ վճռի սպասումով. ԲՀԿ-ի պայքարը շարունակվում է
ՍԴ վճռի սպասումով. ԲՀԿ-ի պայքարը շարունակվում է
 ՌԴ ԱԳՆ պաշտոնական մեկնաբանությունը ցույց են տալիս, որ ՀԱՊԿ-ի շուրջ ճգնաժամին հետևում է նաև ԵԱՏՄ-ի շուրջ ճգնաժամը․ Տիգրան Աբրահամյան
ՌԴ ԱԳՆ պաշտոնական մեկնաբանությունը ցույց են տալիս, որ ՀԱՊԿ-ի շուրջ ճգնաժամին հետևում է նաև ԵԱՏՄ-ի շուրջ ճգնաժամը․ Տիգրան Աբրահամյան
 «ՀայաՔվեի» մեծ ընտանիքի շարքերը կուռ են և անսասան
«ՀայաՔվեի» մեծ ընտանիքի շարքերը կուռ են և անսասան
 «Ժողովրդավարության բաստիոնից» մնաց միայն «բաստիոնը»՝ ժանգոտած ավտորիտարիզմով. «Փաստ»1
«Ժողովրդավարության բաստիոնից» մնաց միայն «բաստիոնը»՝ ժանգոտած ավտորիտարիզմով. «Փաստ»1
 ԱՄՆ ԶՈւ-ն հայտնել են Իրանին hարվածելու մասին
2
ԱՄՆ ԶՈւ-ն հայտնել են Իրանին hարվածելու մասին
2
 Մադոննան պատմել է, թե ինչպես է կարողացել վերականգնել հարաբերությունները ավագ դստեր՝ 29-ամյա Լուրդեսի...3
Մադոննան պատմել է, թե ինչպես է կարողացել վերականգնել հարաբերությունները ավագ դստեր՝ 29-ամյա Լուրդեսի...3
 Ընտրությունը «ջրեց» նաև հակառուսականության միֆը. «Փաստ»4
Ընտրությունը «ջրեց» նաև հակառուսականության միֆը. «Փաստ»4
Աշոտ Մելիքյանին հիշեցնենք՝ մեր խմբագրությունը զբաղվում է բացառապես լրատվական գործունեությամբ5
Աշոտ Մելիքյանին հիշեցնենք՝ մեր խմբագրությունը զբաղվում է բացառապես լրատվական գործունեությամբ5



